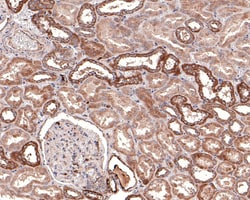

Promotional price valid on web orders only. Your contract pricing may differ. Interested in signing up for a dedicated account number?
Learn More
Learn More
Invitrogen™ DTYMK Recombinant Rabbit Monoclonal Antibody (JE64-08)


Rabbit Recombinant Monoclonal Antibody
Supplier: Invitrogen™ MA544692
This item is not returnable.
View return policy
Description
DTYMK Recombinant Monoclonal Antibody for Western Blot, ICC/IF, IHC (P)
Thymidylate kinase (DTYMK) catalyzes the phosphorylation of dTMP to form dTDP in the dTTP synthesis pathway for DNA synthesis. DTYMK is essential for DNA synthesis and is an important intermediate enzyme in the pathway of many pyrimidine analog drugs, including 5-Fluorouracil (5-FU), the chemotherapeutic drug of choice for several solid tumors. The human DTYMK gene was isolated via functional complementation of a Saccharomyces cerevisiae cell cycle mutant, cdc8. DTYMK mRNA levels and enzyme activities are regulated at the level of cell cycle and cell growth pathways.
Specifications
| DTYMK | |
| Recombinant Monoclonal | |
| 1 mg/mL | |
| TBS with 0.05% BSA, 40% glycerol and 0.05% sodium azide; pH 7.4 | |
| P23919 | |
| DTYMK | |
| Synthetic peptide within Human DTYMK aa 150-200/212. | |
| 100 μL | |
| Primary | |
| Human | |
| Antibody | |
| IgG |
| Immunohistochemistry (Paraffin), Western Blot, Immunocytochemistry | |
| JE64-08 | |
| Unconjugated | |
| DTYMK | |
| AU044245; CDC8; D10Ertd203e; deoxythymidylate kinase; deoxythymidylate kinase (thymidylate kinase); dTMP kinase; DTYMK; mtmk; PP3731; Thymidylate kinase; Tmk; TMPK; TYMK; TYPK | |
| Rabbit | |
| Protein A | |
| RUO | |
| 1841 | |
| Store at 4°C short term. For long term storage, store at -20°C, avoiding freeze/thaw cycles. | |
| Liquid |
Safety and Handling
WARNING: Cancer - www.P65Warnings.ca.gov
Product Content Correction
Your input is important to us. Please complete this form to provide feedback related to the content on this product.
Product Title
Spot an opportunity for improvement?Share a Content Correction